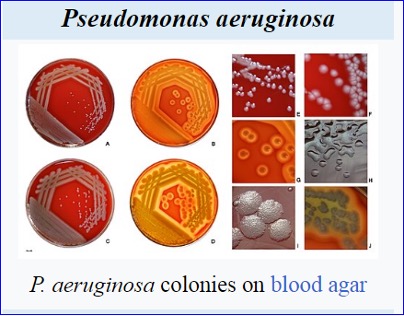

Clarametyx
Clarametyx completes enrolment in cystic fibrosis trial
Clarametyx has concluded subject enrolment in its Phase Ib/IIa study of CMTX-101, an immune-enhancing antibody therapy being developed to treat pulmonary biofilm infections associated with cystic fibrosis.The trial has enrolled 42 individuals ahead of schedule.
Clarametyx is evaluating CMTX-101 in a placebo-controlled, double-blind, randomised manner, alongside standard care therapy for individuals with cystic fibrosis.
The trial aims to assess the tolerability and safety of the treatment, reducing the pulmonary burden of Pseudomonas aeruginosa (P. aeruginosa), along with its immunogenicity, pharmacokinetics and various additional exploratory goals.
Clarametyx CEO David Richards said: “We look forward to sharing topline results in early 2026, which, if positive, will propel us to the next stage of development in multiple chronic respiratory indications and further unlock the potential of CMTX-101.”
Interim data analysis achieved the pre-specified criteria for continuing the trial at dose levels of 5mg/kg as well as 30mg/kg.
Subjects in the study demonstrated a reduction in P. aeruginosa burden based on prespecified statistical criteria. CMTX-101 was detected in the sputum of all subjects who received the treatment. The therapy was generally observed to be well tolerated, aligning with the results reported in a previous trial. No anti-drug antibodies were identified.
The investigational antibody therapy is specifically designed to swiftly destroy the pro-inflammatory structures of bacterial biofilms, thereby weakening the extracellular defences of bacteria.
In June 2025, Clarametyx received Independent Data Monitoring Committee approval to progress the Phase Ib/IIa trial of CMTX-101.